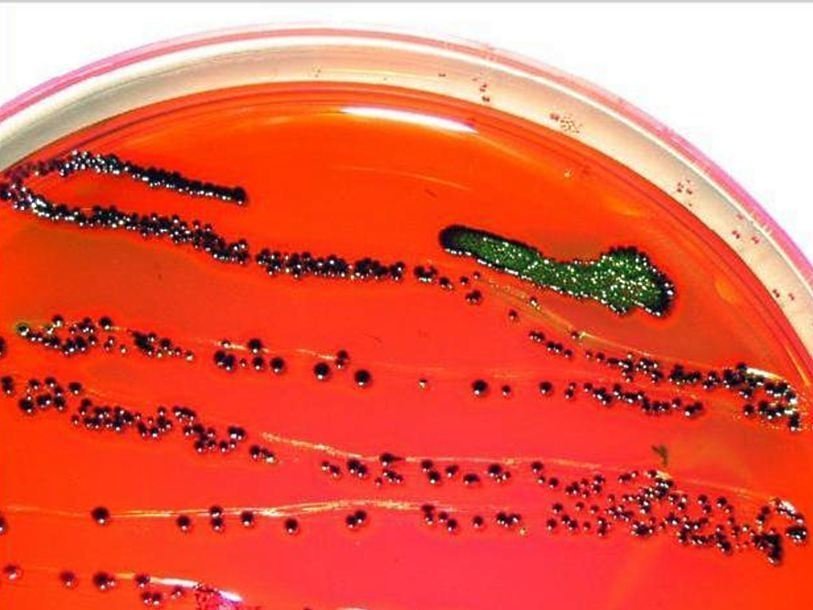

Бактерию научили убивать по команде
Партнер проекта В 2013 году Центр по контролю и профилактике заболеваний США опубликовал доклад об угрозе, которую представляют собой бактерии, приобретшие устойчивость к антибиотикам. Согласно докладу, по меньшей мере два миллиона людей каждый год в США оказываются заражены устойчивыми к антибиотикам бактериями, и 23 тысячи из них умирают. Еще чаще смерть наступает вследствие осложнений, вызванных устойчивой к антибиотикам инфекцией. Снижение эффективности антибиотиков, применение которых и без того вызывает много споров, подталкивает исследователей к поискам новых способов борьбы с патогенами.
По меньшей мере два миллиона людей каждый год в США оказываются заражены устойчивыми к антибиотикам бактериями.Главная причина возникновения устойчивости к антибиотикам у бактерий – это использование антибиотиков. Чаще всего, неправильное или избыточное. Конечно, какие-то формы устойчивости существовали еще до начала массового применения антибиотиков, распространение лекарств создало сильное давление отбора и направило эволюцию бактерий в сторону создания новых форм. Действительно, в ситуации, когда у бактерии есть два варианта: оказаться устойчивой к антибиотику или погибнуть, все возникающие мутации, обеспечивающие устойчивость, дают огромное преимущество своим обладателям. Только такие бактерии будут беспечно размножаться при действием антибиотика и передавать свои гены следующим поколениям. Мутации же, благодаря недостаточной точности копирования генома, происходят постоянно с определенной частотой. В стрессовых условиях эта частота даже может заметно возрастать. В целом, выгоднее увеличить шансы на возникновение хорошо приспособленной к новым условиям особи, даже повысив при этом шансы на возникновение нежизнеспособных и просто плохо приспособленных.
Бактерия синегнойная палочка Угроза того, что антибиотики могут оказаться бессильными, заставляет ученых придумывать все более оригинальные методы борьбы с инфекциями. Так, группа Мэтью Чана (Matthew Wook Chang) из Наньянского технологического университета в Сингапуре пытается вооружить обычно безвредную, обитающую в желудочно-кишечном тракте теплокровных существ бактерию Esherichia coli (E. coli) для борьбы с синегнойной палочкой (Pseudomonas aeruginosa, P. aeruginosa). Синегнойная палочка может вызывать воспаление легких, цистит, обнаруживается при абсцессах и гнойных ранах. Она особенно опасна для людей с пониженным иммунитетом и часто является причиной внутрибольничных инфекций – главного источника устойчивых к антибиотикам штаммов бактерий. Способность образовывать труднопроницаемые биопленки делает ее еще более опасной с точки зрения развития устойчивости к антибиотикам.
При встрече с врагом бактериивзрывались, и яд оказывался снаружи.В более ранней работе E. coli были генетически модифицированы так, чтобы синтезировать и накапливать внутри себя белок, избирательно убивающий синегнойную палочку – пиоцин. При встрече с врагом E. coli взрывались, и яд оказывался снаружи. Хотя in vitro E. coli неплохо справлялись, этот метод был признан недостаточно точным, аккуратным и безопасным для использования in vivo.
В 2013 году ученые пошли дальше, научив E. coli выслеживать, преследовать и убивать синегнойную палочку. Для этого в геном бактерий были внесены три изменения. Вместо гена пиоцина был введен ген белка микроцина S. Микроцин S меньше по размеру и способен выбираться из клетки наружу через мембрану сам. Это избавило E. сoli от участи камикадзе. Другим оружием E. coli стала ДНКаза I – фермент, способный разрушать дезоксирибонуклеиновые кислоты, за счет которых достигается прочность и непроницаемость биопленок.
Наконец, E. сoli надо было снабдить системой для выслеживания синегнойных палочек. В этом помогли сами патогены. Для контроля своей численности и плотности популяции они пользуются специальной сигнальной молекулой. Все бактерии P. aeruginosa выделяют их в окружающую среду, и все способны оценивать их концентрацию. На основании этого бактерии принимают решения, делиться дальше или, наоборот, объявлять режим жесткой экономии. В клетки E. сoli был встроен ген, кодирующий белок, взаимодействующий с этой сигнальной молекулой. Это взаимодействие активирует синтез микроцина и ДНКазы и, кроме того, управляет движением E.coli – бактерии начинают двигаться туда, где больше врагов (и концентрация сигнальной молекулы выше).
У мышей, зараженных синегнойной палочкой, употребление модифицированных E. сoli в пищу привело к снижению количества патогенов, не вызвало видимых побочных эффектов и предотвратило развитие симптомов заболевания.
Дополнительное удобство состоит в том, что модифицированные E. coli могут работать сторожами. Они будут спокойно существовать в желудочно-кишечном тракте человека с высокой степенью риска заболеваний, вызываемых синегнойной палочкой, и активизироваться только в случае развития заболевания.